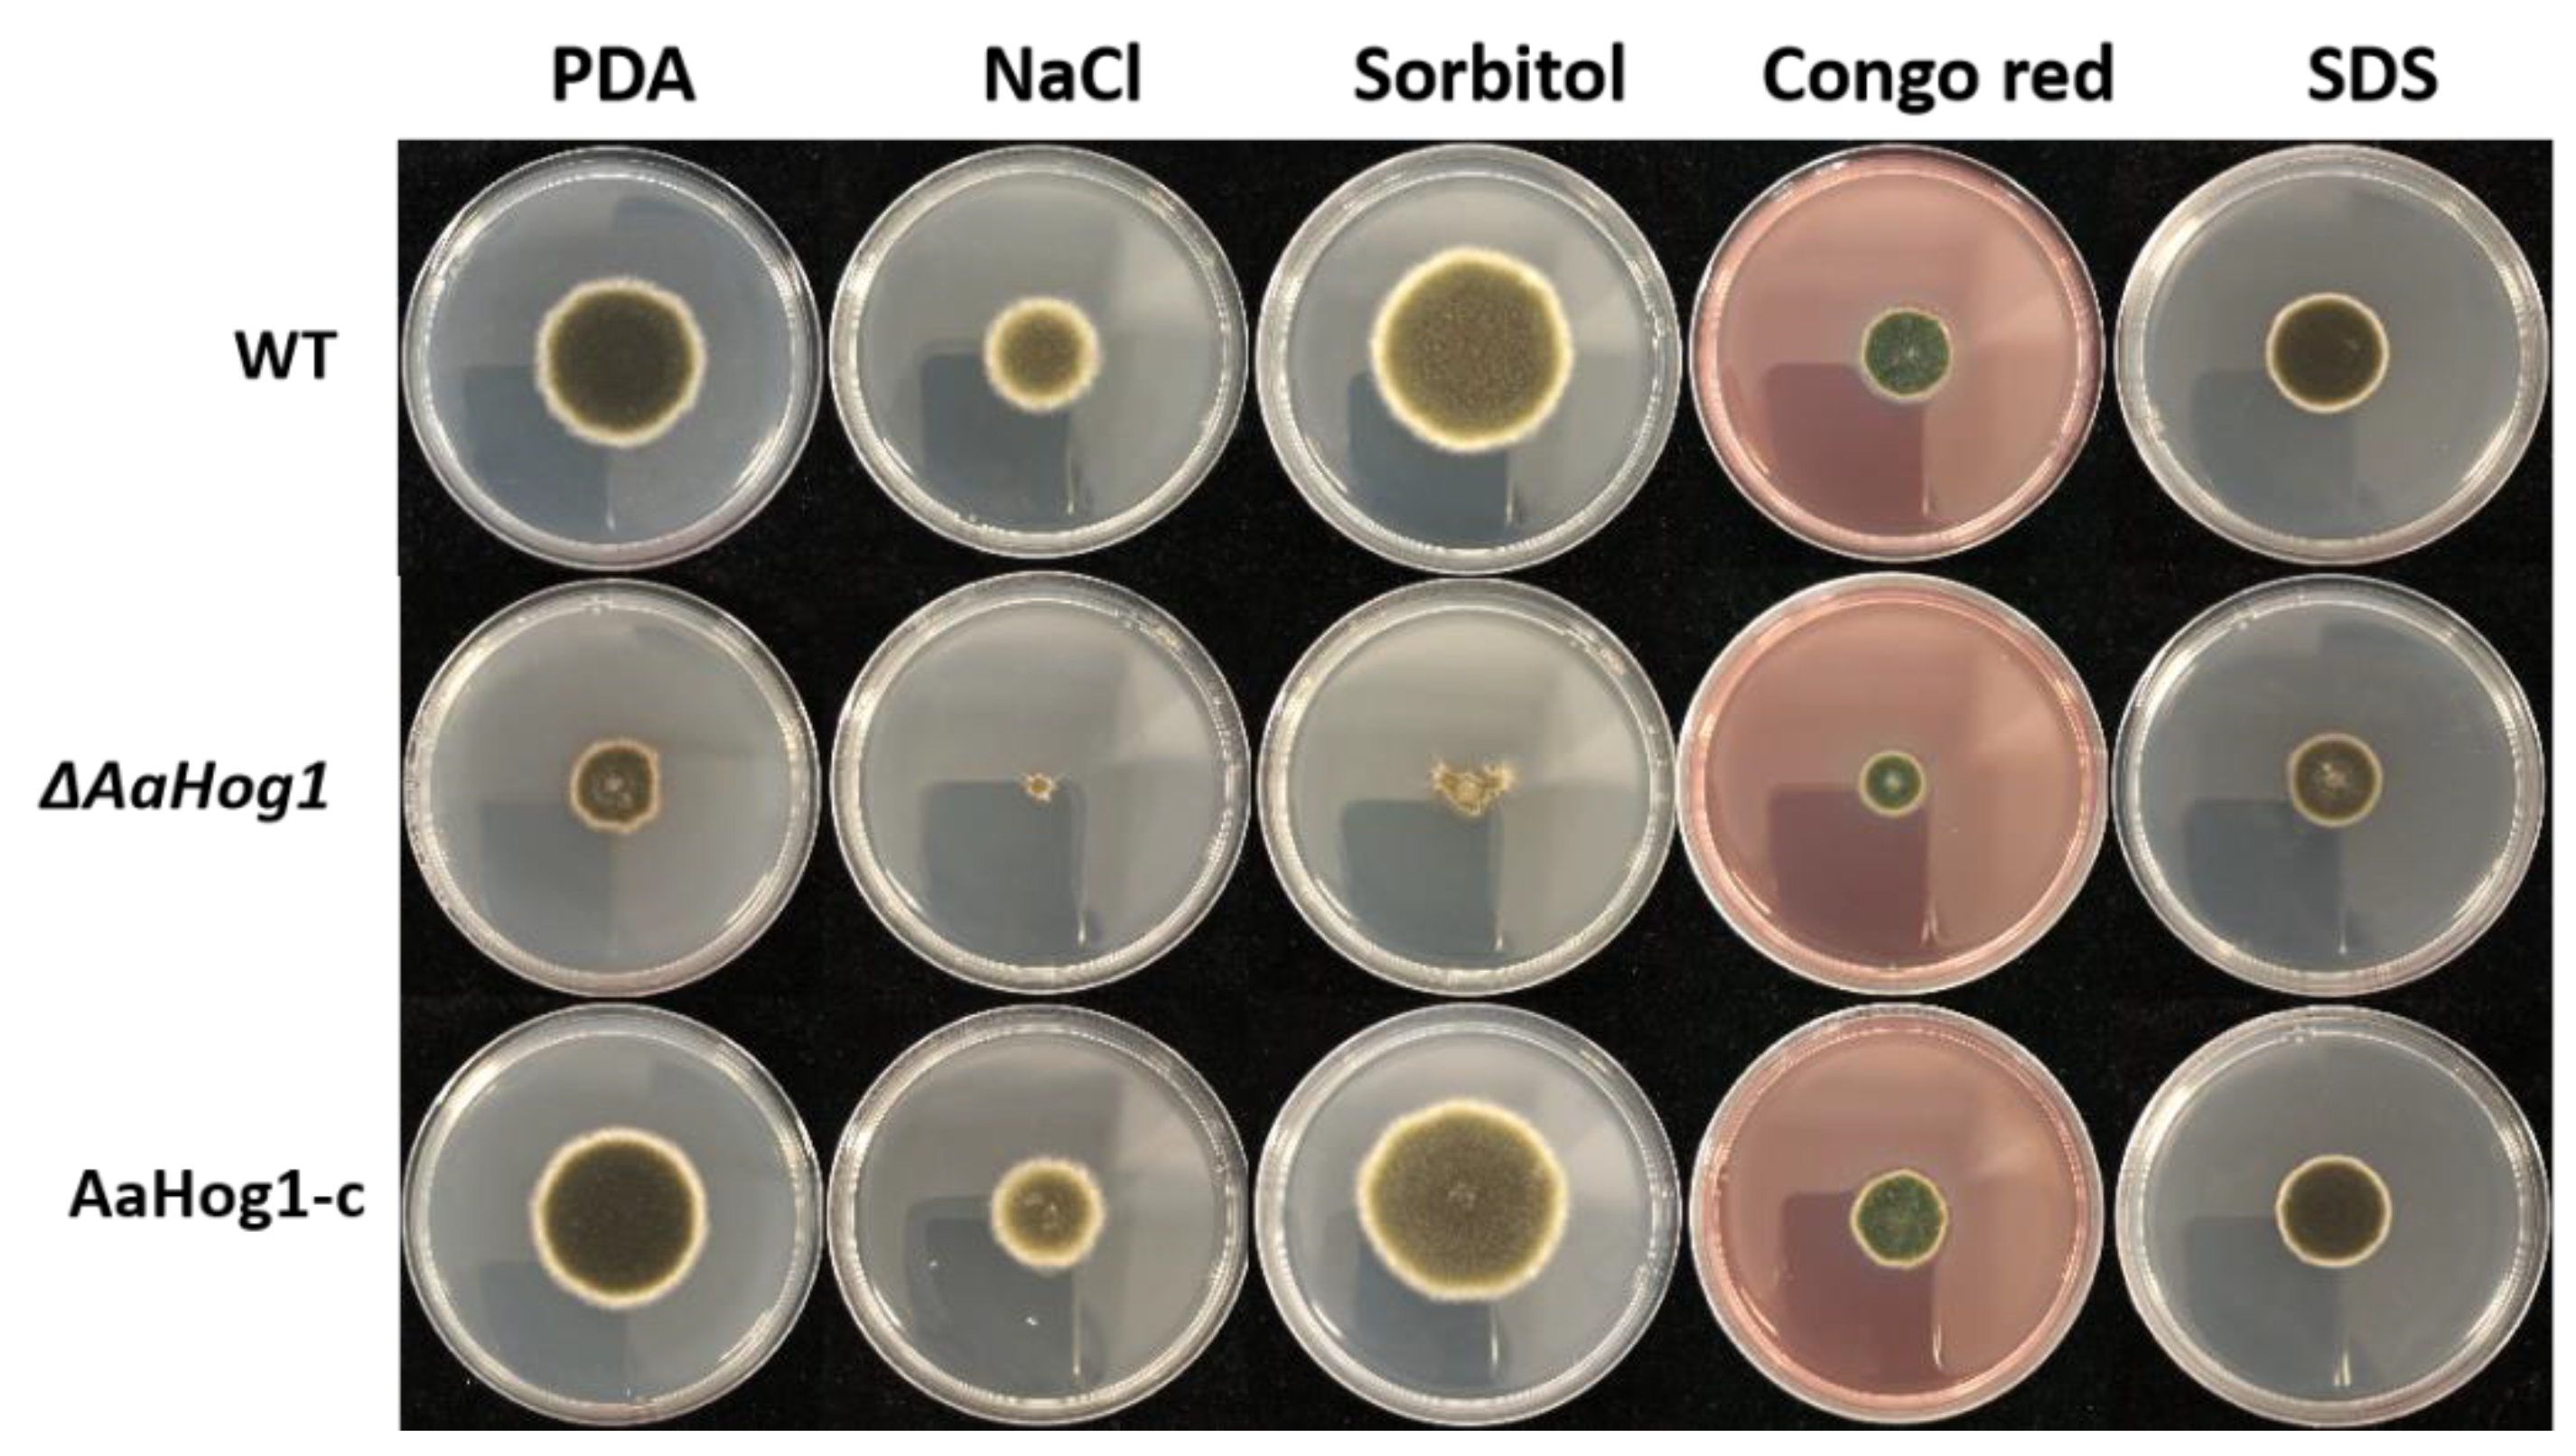

AaHog1 Regulates Infective Structural Differentiation Mediated by Physicochemical Signals from Pear Fruit Cuticular Wax, Stress Response, and Alternaria alternata Pathogenicity
Abstract
:1. Introduction
2. Materials and Methods
2.1. Fungal Strains
2.2. Construction of Plasmid Vectors for ΔAaHog1 and AaHog1-c
2.3. Quantitative RT-PCR Analysis
2.4. Extraction of Fruit Wax
2.5. Infection Structure Formation Assays
2.6. Growth and Development Phenotype Analysis
2.7. Stress Response
2.8. Virulence Determination
2.9. Cell-Wall-Degrading Enzyme Activity Analysis
2.10. Statistical Analysis
3. Results
3.1. Characterization and Identification of the AaHog1-MAP Kinase
3.2. Gene Expression
3.3. AaHog1-MAPK Is Important for Infective Structure Formation Induced by Physicochemical Cues from the Pear Fruit Surface
3.4. AaHog1 Is Important for A. alternata Growth, Development and Stress Response
3.5. AaHog1 Is Indispensable for A. alternata Virulence
3.6. AaHog1 Positive Regulates Cell-Wall-Degrading Enzyme Activity
4. Discussion
Supplementary Materials
Author Contributions
Funding
Institutional Review Board Statement
Informed Consent Statement
Data Availability Statement
Conflicts of Interest
References
- Pan, T.T.; Pu, H.B.; Sun, D.W. Insights into the changes in chemical compositions of the cell wall of pear fruit infected by Alternaria alternata with confocal raman microspectroscopy. Postharvest Biol. Technol. 2017, 132, 119–129. [Google Scholar] [CrossRef]
- Tang, Y.; Li, Y.C.; Bi, Y.; Wang, Y. Role of pear fruit cuticular wax and surface hydrophobicity in regulating the prepenetration phase of Alternaria alternata infection. J. Phytopathol. 2017, 165, 313–322. [Google Scholar] [CrossRef]
- O’Connell, R.J.; Thon, M.R.; Hacquard, S.; Amyotte, S.G.; Kleemann, J.; Torres, M.F. Life style transitions in plant pathogenic Colletotrichum fungi deciphered by genome and transcriptome analyses. Nat. Genet. 2012, 44, 1060–1065. [Google Scholar] [CrossRef] [PubMed]
- Fetzner, R.; Seither, K.; Wenderoth, M.; Herr, A.; Fischer, R. Alternaria alternata transcription factor cmra controls melanization and spore development. Microbiology 2014, 160, 1845–1854. [Google Scholar] [CrossRef] [Green Version]
- Liu, H.; Suresh, A.; Willard, F.S.; Siderovski, D.P.; Lu, S.; Naqvi, N.I. Rgs1 regulates multiple Ga subunits in Magnaporthe pathogenesis, asexual growth and thigmotropism. EMBO J. 2007, 26, 690–700. [Google Scholar] [CrossRef] [PubMed] [Green Version]
- Iwamoto, M.; Takeuchi, Y.; Takada, Y.; Yamaoka, N. Coleoptile surface cuticle of barley is involved in survival and penetration of Blumeria graminis. Physiol. Mol. Plant Pathol. 2002, 60, 31–38. [Google Scholar] [CrossRef]
- Kou, Y.; Naqvi, N.I. Surface sensing and signaling networks in plant pathogenic fungi. Semin. Cell Dev. Biol. 2016, 57, 84–92. [Google Scholar] [CrossRef]
- Kou, Y.; Tan, Y.H.; Ramanujam, R.; Naqvi, N.I. Structure-function analyses of the pth11 receptor reveal an important role for CFEM motif and redox regulation in rice blast. New Phytol. 2017, 214, 330–342. [Google Scholar] [CrossRef]
- Selvaraj, P.; Hong, F.T.; Ramanujam, R.; Naqvi, N. Subcellular compartmentation, interdependency and dynamics of the cyclic AMP-dependent PKA subunits during pathogenic differentiation in rice blast. Mol. Microbiol. 2017, 105, 484–504. [Google Scholar] [CrossRef] [Green Version]
- Feng, J.; Wang, F.; Liu, G.; Greenshields, D.; Shen, W.; Kaminskyj, S. Analysis of a Blumeria graminis secreted lipase reveals the importance of host epicuticular wax components for fungal adhesion and development. Mol. Plant Microbe Int. 2009, 22, 1601–1610. [Google Scholar] [CrossRef] [Green Version]
- Mendoza-Mendoza, A.; Berndt, P.; Djamei, A.; Weise, C.; Linne, U.; Marahiel, M.; Kämper, J.; Kahmann, R. Physical-chemical plant-derived signals induce differentiation in Ustilago maydis. Mol. Microbiol. 2009, 71, 895–911. [Google Scholar] [CrossRef] [PubMed]
- Chagué, V.; Danit, L.V.; Siewers, V.; Schulze-Gronover, C.; Tudzynski, P.; Tudzynski, B. Ethylene sensing and gene activation in Botrytis cinerea: A missing link in ethylene regulation of fungus-plant interactions? Mol. Plant Microbe Int. 2006, 19, 33. [Google Scholar] [CrossRef] [PubMed] [Green Version]
- Talbot, N.J. On the trail of a cereal killer: Exploring the biology of Magnaporthe grisea. Annu. Rev. Microbiol. 2003, 57, 177–202. [Google Scholar] [CrossRef] [PubMed] [Green Version]
- Versele, M.; Lemaire, K.; Thevelein, J.M. Sex and sugar in yeast: Two distinct GPCR systems. EMBO Rep. 2001, 2, 574–579. [Google Scholar] [CrossRef] [Green Version]
- Jiang, C.; Cao, S.; Wang, Z.; Xu, H.; Liang, J.; Liu, H.; Wang, G.; Ding, M.; Wang, Q.; Gong, C.; et al. An expanded subfamily of G-protein-coupled receptor genes in Fusarium graminearum required for wheat infection. Nat. Microbiol. 2019, 4, 1582–1591. [Google Scholar] [CrossRef]
- Liu, W.; Zhou, X.; Li, G.; Li, L.; Kong, L.G.; Wang, C.F.; Zhang, H.F.; Xu, J.R.; Howlett, B.J. Multiple plant surface signals are sensed by different mechanisms in the rice blast fungus for appressorium formation. PLoS Pathog. 2011, 7, e1001261. [Google Scholar] [CrossRef] [Green Version]
- Molina, M.; Cid, V.J.; Martín, H. Fine regulation of Saccharomyces cerevisiae MAPK pathways by post-translational modifications. Yeast 2010, 27, 503–511. [Google Scholar] [CrossRef] [Green Version]
- Alonso, M.R.; Carvaihlo, S.; Nombela, C.; Rial, E.; Pla, J. The Hogl MAP kinase controls respiratory metabolism in the fungal pathogen Candida albicans. Microbiology 2009, 155, 413–423. [Google Scholar] [CrossRef] [Green Version]
- Kojima, K.; Kikuchi, T.; Takano, Y.; Oshiro, E.; Okuno, T. The mitogen activated protein kinase gene MAF1 is essential for the early differentiation phase of appressorium formation in Colletotrichum lagenarium. Mol. Plant Microbe Int. 2003, 15, 1268–1276. [Google Scholar] [CrossRef]
- Moriwaki, A.; Kubo, E.; Arase, S.; Kihara, J. Disruption of SRM1, a mitogen-activated protein kinase gene, affects sensitivity to osmotic and ultraviolet stressors in the phytopathogenic fungus Bipolaris oryzae. FEMS Microbiol. Lett. 2006, 257, 253–261. [Google Scholar] [CrossRef] [Green Version]
- Van, T.N.; Schafer, W.; Bormann, J. The stress-activated protein kinase Fgos-2 is a key regulator in the life cycle of the cereal pathogen Fusarium graminearum. Mol. Plant Microbe Int. 2012, 25, 1142–1156. [Google Scholar] [CrossRef] [Green Version]
- Park, S.M.; Choi, E.S.; Kim, M.J.; Cha, B.J.; Yang, M.S.; Kim, D.H. Characterization of Hog1 homologue, CPmk1, from Fryphonectria parasitica and evidence for hypovirus-mediated perturbation of its phosphorylation in response to hypertonic stress. Mol. Microbiol. 2004, 51, 1267–1277. [Google Scholar] [CrossRef] [PubMed]
- Adám, A.L.; Kohut, G.; Hornok, L. FPhog1, a HOG-type MAP kinase gene, is involved in multistress response in Fusarium proliferatum. J. Basic Microb. 2010, 48, 151–159. [Google Scholar] [CrossRef] [PubMed]
- Kawasaki, L.; Sanchez, O.; Shiozaki, K.; Aguirre, J. Saka MAP kinase is involved in stress signal transduction, sexual development and spore viability in Aspergillus nidulans. Mol. Mocrobiol. 2002, 45, 1153–1163. [Google Scholar] [CrossRef]
- Wei, W.; Xiong, Y.; Zhu, W.; Wang, N.; Yang, G.; Peng, F. Colletotrichum higginsianum mitogen-activated protein kinase ChMK1: Role in growth, cell wall integrity, colony melanization, and pathogenicity. Front. Microbiol. 2016, 7, 1212. [Google Scholar] [CrossRef] [Green Version]
- Chen, Y.; Li, B.Q.; Xu, X.D.; Zhang, Z.Q.; Tian, S.P. The pH responsive PacC transcription factor plays pivotal roles in virulence and patulin biosynthesis in Penicillium expansum. Environ. Microbiol. 2018, 20, 4063–4078. [Google Scholar] [CrossRef]
- Livak, K.J.; Schmittgen, T.D. Analysis of relative gene expression data using real-time quantitative PCR and the 2 −ΔΔct method. Methods 2001, 25, 402–408. [Google Scholar] [CrossRef]
- Belding, R.D.; Sutton, T.B.; Blankenship, S.M.; Young, E. Relationship between apple fruit epicuticular wax and growth of Peltaster fructicola and Leptodontidium elatius, two fungi that cause sooty blotch disease. Plant Dis. 2000, 84, 767–772. [Google Scholar] [CrossRef] [Green Version]
- Xu, D.D.; Deng, Y.Z.; Han, T.Y.; Jiang, L.Q.; Xi, P.G.; Wang, Q.; Jiang, Z.; Gao, L. In vitro and in vivo effectiveness of phenolic compounds for the control of postharvest gray mold of table grapes. Postharvest Biol. Technol. 2018, 139, 106–114. [Google Scholar] [CrossRef]
- Li, H.; Zhang, Z.Q.; He, C.; Qin, G.Z.; Tian, S.P. Comparative proteomics reveals the potential targets of BcNoxR, a putative regulatory subunit of NADPH oxidase of Botrytis cinerea. Mol. Plant Microbe Int. 2016, 29, 990–1003. [Google Scholar] [CrossRef] [Green Version]
- Chiu, C.M.; You, B.J.; Chou, C.M.; Yu, P.L.; Lee, M.H. Redox status-mediated regulation of gene expression and virulence in the brown rot pathogen Monilinia fructicola. Plant Pathol. 2013, 62, 809–819. [Google Scholar] [CrossRef]
- Yoshida, O.; Nakagawa, H.; Ogura, N.; Sato, T. Effect of heat treatment on the development of polygalacturonase activity in tomato fruit during ripening. Plant Cell Physiol. 1984, 25, 505–509. [Google Scholar] [CrossRef]
- Francis, S.A.; Dewey, F.M.; Gurr, S.J. The role of cutinase in germling development and infection by Erysiphe graminis f.sp. hordei. Physiol. Mol. Plant Pathol. 1996, 49, 201–211. [Google Scholar] [CrossRef]
- Xu, J.R. MAP Kinases in fungal pathogens. Fungal Genet. Biol. 2000, 31, 137–152. [Google Scholar] [CrossRef] [PubMed]
- Joubert, A.; Bataille, S.N.; CamPion, C.; Guillemette, T.; Hudhomme, P.; Iacomi, V.B.; Pochon, S.; Poupard, P.; Simoneau, P. Cell wall integrity and high osmolarity glycerol pathways are required for adaptation of Alternaria brassicicola to cell wall stress caused by brassicaceous indolic phytoalexins. Cell Microbiol. 2011, 13, 62–80. [Google Scholar] [CrossRef] [PubMed] [Green Version]
- Jiang, C.; Zhang, X.; Liu, H.; Xu, J.R. Mitogen-activated protein kinase signaling in plant pathogenic fungi. PLoS Pathog. 2018, 14, e1006875. [Google Scholar] [CrossRef] [Green Version]
- Li, G.; Zhou, X.; Xu, J.R. Genetic control of infection-related development in Magnaporthe oryzae. Curr. Opin. Microbiol. 2012, 15, 678–684. [Google Scholar] [CrossRef]
- Liu, S.H.; Dean, R.A. G Protein alpha subunit genes control growth, development, and pathogenicity of Magnaporthe grisea. Mol. Plant Microbe Interact. 1997, 10, 1075–1086. [Google Scholar] [CrossRef] [Green Version]
- Ren, J.Y.; Li, C.L.; Gao, C.Y.; Xu, J.R.; Jiang, C.; Wang, G.H. Deletion of FgHOG1 is suppressive to the mgv1 mutant by stimulating Gpmk1 activation and avoiding intracellular turgor elevation in Fusarium graminearum. Front. Microbiol. 2019, 10, 1073. [Google Scholar] [CrossRef]
- Lin, C.H.; Chung, K.R. Specialized and shared functions of the histidine kinase-and HOG1 MAP kinase-mediated signaling Pathways in Alternaria alternata, a filamentous fungal pathogen of citrus. Fungal Genet. Biol. 2010, 47, 827. [Google Scholar] [CrossRef]
- Zhu, W.J.; Man, Z.; Ze, Y.X.; Fang, P.; Wei, W. The cAMP-PKA signaling pathway regulates pathogenicity, hyphal growth, appressorial formation, conidiation, and stress tolerance in Colletotrichum higginsianum. Front. Microbiol. 2017, 8, 1416. [Google Scholar] [CrossRef] [PubMed] [Green Version]
- Igbaria, A.; Lev, S.; Rose, M.S.; Lee, B.N.; Hadar, R.; Degani, O.; Horwitz, B.A. Distinct and combined roles of the MAP kinases of Cochliobolus heterostrophus in virulence and stress responses. Mol. Plant Microbe Int. 2008, 21, 769–780. [Google Scholar] [CrossRef] [PubMed] [Green Version]
- Leng, Y.Q.; Zhong, S.B. The role of mitogen-activated protein (MAP) kinase signaling components in the fungal development, stress response and virulence of the fungal cereal pathogen Bipolaris sorokiniana. PLoS ONE 2015, 10, e0128291. [Google Scholar] [CrossRef] [PubMed] [Green Version]
- Hubballi, M.; Sornakili, A.; Nakkeeran, S.; Anand, T.; Raguchander, T. Virulence of Alternaria alternata infecting noni associated with production of cell wall degrading enzymes. J. Plant Prot. Res. 2011, 51, 87–92. [Google Scholar] [CrossRef]
- Zheng, D.W.; Wang, Y.; Han, Y.; Xu, J.R.; Wang, C.F. UvHOG1 is important for hyphal growth and stress responses in the rice false smut fungus Ustilaginoidea virens. Sci. Rep. 2016, 6, 24824. [Google Scholar] [CrossRef] [PubMed]

| Treatment | Percentage of Inhibition (%) | ||
|---|---|---|---|
| WT | ΔAaHog1 | AaHog1-c | |
| PDA | - | 40.31 ± 0.02 A | 0.20 ± 0.05 B |
| 1 mol L−1 NaCl | 41.35 ± 0.1 B | 87.25 ± 0.02 A | 44.21 ± 0.03 B |
| 1 mol−1 Sorbitol | −32.08 ± 0.06 C | 66.76 ± 0.01 A | −28.42 ± 0.06 B |
| 10 μmol−1 Congo red | 49.32 ± 0.08 B | 64.75 ± 0.03 A | 51.47 ± 0.07 B |
| 1 mol−1 SDS | 36.33 ± 0.06 B | 51.55 ± 0.03 A | 38.19 ± 0.06 B |
Publisher’s Note: MDPI stays neutral with regard to jurisdictional claims in published maps and institutional affiliations. |
© 2022 by the authors. Licensee MDPI, Basel, Switzerland. This article is an open access article distributed under the terms and conditions of the Creative Commons Attribution (CC BY) license (https://creativecommons.org/licenses/by/4.0/).
Share and Cite
Zhang, M.; Wang, T.; Li, Y.; Bi, Y.; Li, R.; Yuan, J.; Xu, W.; Prusky, D. AaHog1 Regulates Infective Structural Differentiation Mediated by Physicochemical Signals from Pear Fruit Cuticular Wax, Stress Response, and Alternaria alternata Pathogenicity. J. Fungi 2022, 8, 266. https://doi.org/10.3390/jof8030266
Zhang M, Wang T, Li Y, Bi Y, Li R, Yuan J, Xu W, Prusky D. AaHog1 Regulates Infective Structural Differentiation Mediated by Physicochemical Signals from Pear Fruit Cuticular Wax, Stress Response, and Alternaria alternata Pathogenicity. Journal of Fungi. 2022; 8(3):266. https://doi.org/10.3390/jof8030266
Chicago/Turabian StyleZhang, Miao, Tiaolan Wang, Yongcai Li, Yang Bi, Rong Li, Jing Yuan, Wenyi Xu, and Dov Prusky. 2022. "AaHog1 Regulates Infective Structural Differentiation Mediated by Physicochemical Signals from Pear Fruit Cuticular Wax, Stress Response, and Alternaria alternata Pathogenicity" Journal of Fungi 8, no. 3: 266. https://doi.org/10.3390/jof8030266
APA StyleZhang, M., Wang, T., Li, Y., Bi, Y., Li, R., Yuan, J., Xu, W., & Prusky, D. (2022). AaHog1 Regulates Infective Structural Differentiation Mediated by Physicochemical Signals from Pear Fruit Cuticular Wax, Stress Response, and Alternaria alternata Pathogenicity. Journal of Fungi, 8(3), 266. https://doi.org/10.3390/jof8030266









